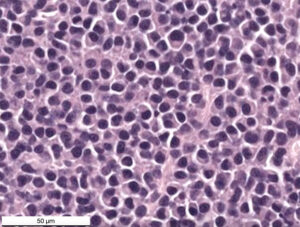

The cells had eccentric nuclei with stippled to clumped chromatin and no nucleoli. They had a moderate amount of amphophilic cytoplasm with a perinuclear clear zone. They displayed mild to moderate anisokaryosis but no mitoses were seen in ten 2.37 mm2 fields. The morphologic diagnosis from the cryostat histopathologic section was a plasma cell tumor.